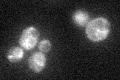
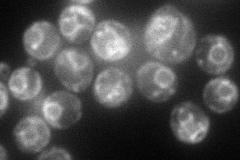
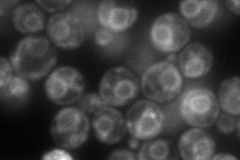
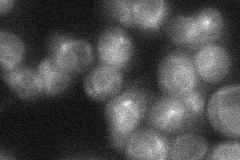
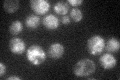

View description
Protein involved in ER-associated protein degradation; proposed to coordinate the assembly of proteins involved in ERAD; contains a UBX (ubiquitin regulatory X) domain and a ubiquitin-associated (UBA) domain
Localization:
Intensity:
Fold change:
Significance:
-
C’ GFP library in SD
ER35.85 -
N' NOP1pr-GFP in SD
ER96.9473 -
N' TEF2pr-mCherry in SD
ER138.558 -
N' NATIVEpr-GFP in SD
ER31.5841 -
N' TEF2pr-VC and Cyto-VN in SD

ER41.3867 -
C’ GFP library in SD+DTT

ER44.821.24No -
C’ GFP library in SD+H2O2

ER42.611.18No -
C’ GFP library in Starvation Media
ER45.491.26No -
C’ GFP library on the background of Pup2-DaMP

ER -
C’ GFP library on the background of CCT mutant

ER46.65681.301No
